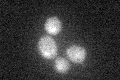
YER028C
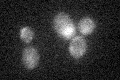
YER028C

View description
Probable transcriptional repressor involved in response to toxic agents such as hydroxyurea that inhibit ribonucleotide reductase; phosphorylation by Snf1p or the Mec1p pathway inactivates Mig3p, allowing induction of damage response genes
Localization:
Intensity:
Fold change:
Significance:
-
C’ GFP library in SD
nucleus17.93 -
N' NOP1pr-GFP in SD

nucleus41.1932 -
N' TEF2pr-mCherry in SD

nucleus16.5855 -
N' NATIVEpr-GFP in SD

below threshold21.7584 -
N' TEF2pr-VC and Cyto-VN in SD

below threshold23.5282 -
C’ GFP library in SD+DTT

nucleusN/AN/ANo -
C’ GFP library in SD+H2O2
nucleusN/AN/ANo -
C’ GFP library in Starvation Media

nucleusN/AN/AYes -
C’ GFP library on the background of Pup2-DaMP

nucleus -
C’ GFP library on the background of CCT mutant

nucleusN/AN/ANo
